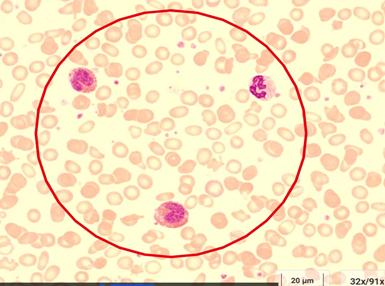
© eLCH Curriculum Hämatologie DGHO
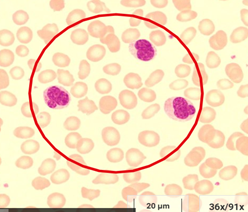
© eLCH Curriculum Hämatologie DGHO

Myeloid/Lymphoid Neoplasm with PDGFRA Rearrangement

Myeloid/Lymphoid Neoplasm with PDGFRA Rearrangement
cytogenetically cryptic (submicroscopic) deletion at 4q12
Ein 50-jähriger asymptomatischer Mann stellte sich mit einer zufällig festgestellten Leukozytose, Hypereosinophilie (8,5 × 109/L), Neutrophilie, Basophilie, leichter Anämie und Thrombozytopenie vor. Die Knochenmarkbiopsie zeigte eine Hyperzellularität mit deutlich erhöhten neutrophilen und eosinophilen Zelllinien, die nach links verschoben waren, jedoch eine vollständige Reifung aufwiesen. Die Chromosomenanalyse des Knochenmarks ergab einen normalen Karyotyp in allen 20 analysierten Zellen (Abbildung 1). Das FISH-Panel zur Diagnose einer chronischen Eosinophilie wurde ebenfalls angefordert, und repräsentative Zellkerne aus jedem Probeset sind in Abbildung 2 dargestellt. Die genomische Konfiguration der FIP1L1-CHIC2-PDGFRA-Region ist in Abbildung 3 dargestellt
Myeloid-lymphatische Neoplasien mit Eosinophilie (MLN-eo) und Tyrosinkinase-Genfusionen (MLN-TK) bilden eine seltene Gruppe hämatologischer Malignome. Der onkogene Mechanismus beruht auf der Fusion des 3'-Endes eines Tyrosinkinase-Gens (das die Kinasedomäne enthält) mit dem 5'-Ende eines Partnergens, was zu einer konstitutiven Kinase-Aktivierung und einer unkontrollierten Zellproliferation führt.
Die klinischen Manifestationen sind variabel und unspezifisch. Im peripheren Blut kann die Eosinophilenzahl von normal bis erhöht reichen, mit oder ohne morphologische Anomalien. Eine Monozytose kann ebenfalls vorliegen. Das Knochenmark zeigt typischerweise eine Hyperzellularität mit einer vorwiegend myeloischen Linie, variabel erhöhten Eosinophilen, unspezifischer Dysplasie in allen Linien und häufig Fibrose.
Serummarker wie Tryptase, Vitamin B12 und Laktatdehydrogenase (LDH) können erhöht sein, sind jedoch unspezifisch. Die Blastenphase kann myeloische, lymphoide oder gemischte Phänotypen aufweisen, und es kann zu einer extramedullären Erkrankung kommen.
Es ist wichtig zu beachten, dass eine Eosinophilie weder ausreichend noch notwendig für die Diagnose ist. Die Mayo Clinic Laboratories haben einen Diagnosealgorithmus für Eosinophilie entwickelt (Link: https://www.mayocliniclabs.com/-/media/it-mmfiles/Special-Instructions/F/9/B/Eosinophilia-Bone-Marrow-Diagnostic-Algorithm)
Das myeloische/lymphoide Neoplasma mit PDGFRA-Rearrangement ist die häufigste Form mit einer jährlichen Inzidenz von etwa 0,18 Fällen pro Million Einwohner. Es wird typischerweise durch eine etwa 800 kb große, zytogenetisch kryptische (submikroskopische) Deletion an 4q12 verursacht, die die CHIC2-Genregion entfernt und zur FIP1L1::PDGFRA-Fusion führt (Abbildung 3).
An der Mayo Clinic wird ein dreifarbiges FISH-Probeset zum Nachweis dieser genetischen Veränderung verwendet. Diese Sonde ist im FISH-Panel zur Diagnose der chronischen Eosinophilie enthalten. Das normale Muster zeigt zwei dreifarbige Fusionssignale (rot, grün und aqua).
Bei diesem Patienten beobachteten wir ein dreifarbiges Fusionssignal und ein aquagrünes Signal, wobei das rote Signal fehlte (Abbildung 2A), was auf die Deletion von CHIC2 und das Vorhandensein der FIP1L1::PDGFRA-Fusion hinweist. Da diese Deletion zytogenetisch kryptisch ist, überrascht es nicht, dass die Chromosomenanalyse des Knochenmarks unauffällig war (Abbildung 1). Die Ergebnisse aller anderen Probesets im FISH-Panel zur Diagnose chronischer Eosinophilie waren unauffällig (Abbildung 2B–E).
Insgesamt stehen die Befunde bei diesem Patienten im Einklang mit der Diagnose eines myeloischen/lymphoiden Neoplasmas mit PDGFRA-Rearrangement.
Patienten mit dieser Erkrankung kommen für eine gezielte Therapie mit Tyrosinkinase-Inhibitoren in Frage. Die NCCN- und DGHO-Leitlinien empfehlen derzeit in der chronischen Phase Imatinib 100 mg täglich zur Behandlung. Diese Patienten haben im Allgemeinen eine ausgezeichnete Prognose mit einer 10-Jahres-Überlebensrate von 84 %.
Für weitere Informationen senden Sie bitte eine E-Mail an: sng@sng-consult.de
Quellenangaben
- Qiliang (Andy) Ding, Ph.D. Fellow, Laboratory Genetics and Genomics
Mayo Clinic (Meet Our Fellows - Laboratory Genetics and Genomics Fellowship (Minnesota) - Mayo Clinic College of Medicine & Science, and Qiliang (Andy) Ding - Annual Clinical Genetics Meeting 2026), and Xinjie Xu, Ph.D. (Xinjie Xu, Ph.D. - Doctors and Medical Staff - Mayo Clinic) Consultant, Laboratory Genetics and Genomics Mayo Clinic, Associate Professor of Laboratory Medicine and Pathology, Mayo Clinic College of Medicine and Science - DGHO Deutsche Gesellschaft für Hämatologie und Medizinische Onkologie e.V. Onkopedia Leitlinie 2023: Eosinophilie: Primäre klonale Eosinophile und Differentialdiagnosen
- Reiter A, Metzgeroth G, Cross NCP. How I diagnose and treat myeloid/lymphoid neoplasms with tyrosine kinase gene fusions. Blood. 2025 Apr 17;145(16):1758-1768. doi: 10.1182/blood.2023022417. PMID: 39046810.
- MLL Münchner Leukämielabor GmbH, Max-Lebsche-Platz 31, 81377 München / Germany. MLN-TK: Diagnostische Methoden und ihre Bedeutung, Prognose und Therapie
- © 2026 MLL
- German Study Group for Myeloproliferative Neoplasms (GSG-MPN) und das GSG-MPN-BioRegister (BfArM: drks.de/search/en/trial/DRKS00006035/details)
- OGT – A Sysmex Group Company. CytoCell FIP1L1/CHIC2/PDGFRA Deletion/Fusion FISH Probe. Protocol Video (www.ogt.com/resources/fish-resources-and-support/fish-support/haematology-fish-protocol/).
- Anne Marie Asemissen,
Sabine Haase & DGHO
Deutsche Gesellschaft für Hämatologie und Medizinische Onkologie e.V. / eLCH Curriculum Hämatologie (Account Dr. Simona Nistor-Grahl / ehaematology.com)

Februar/März 2026










